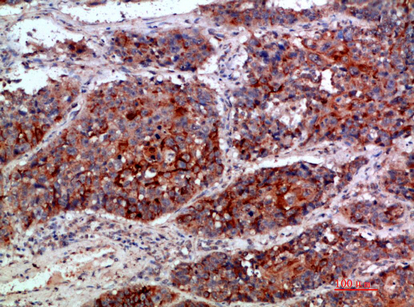

-
分类: 科研抗体货号: P43544别名: Killer cell immunoglobulin-like receptor 3DL2 (CD158 antigen-like family member K) (MHC class I NK cell receptor) (Natural killer-associated transcript 4) (NKAT-4) (p70 natural killer cell receptor clone CL-5) (p70 NK receptor CL-5) (CD antigen CD158k)应用: IHC反应种属: Human
-
分类: 科研抗体货号: P43543别名: CMRF35-like molecule 2 (CLM-2) (CD300 antigen-like family member E) (CMRF35-A5) (Immune receptor expressed on myeloid cells 2) (IREM-2) (Polymeric immunoglobulin receptor 2) (PIgR-2) (PIgR2) (Poly-Ig receptor 2) (CD antigen CD300e)应用: IHC反应种属: Human
-
分类: 科研抗体货号: P43558别名: C-X-C motif chemokine 9 (Gamma-interferon-induced monokine) (Monokine induced by interferon-gamma) (HuMIG) (MIG) (Small-inducible cytokine B9)应用: IHC,IF反应种属: Human,Mouse,Rat
-
分类: 科研抗体货号: P43542别名: Histone-lysine N-methyltransferase MLL (EC 2.1.1.43) (ALL-1) (CXXC-type zinc finger protein 7) (Lysine N-methyltransferase 2A) (KMT2A) (Trithorax-like protein) (Zinc finger protein HRX) [Cleaved into: MLL cleavage product N320 (N-terminal cleavage product应用: IHC反应种属: Human,Mouse,Rat
-
分类: 科研抗体货号: P43557别名: Pro-MCH [Cleaved into: Neuropeptide-glycine-glutamic acid (NGE) (Neuropeptide G-E); Neuropeptide-glutamic acid-isoleucine (NEI) (Neuropeptide E-I); Melanin-concentrating hormone (MCH)]应用: IHC反应种属: Human,Mouse,Rat
-
分类: 科研抗体货号: P43541别名: Angiogenin (EC 3.1.27.-) (Ribonuclease 5) (RNase 5)应用: IHC反应种属: Human
-
分类: 科研抗体货号: P43555别名: 1,2-dihydroxy-3-keto-5-methylthiopentene dioxygenase (EC 1.13.11.54) (Acireductone dioxygenase (Fe(2+)-requiring)) (ARD) (Fe-ARD) (Membrane-type 1 matrix metalloproteinase cytoplasmic tail-binding protein 1) (MTCBP-1) (Submergence-induced protein-like fac应用: IHC反应种属: Human,Mouse,Rat
-
分类: 科研抗体货号: P43540别名: Insulin-like 3 (Leydig insulin-like peptide) (Ley-I-L) (Relaxin-like factor) [Cleaved into: Insulin-like 3 B chain; Insulin-like 3 A chain]应用: IHC反应种属: Human
-
分类: 科研抗体货号: P43554别名: Titin (EC 2.7.11.1) (Connectin) (Rhabdomyosarcoma antigen MU-RMS-40.14)应用: IHC反应种属: Human,Mouse,Rat
-
分类: 科研抗体货号: P43539别名: Integrin alpha-1 (CD49 antigen-like family member A) (Laminin and collagen receptor) (VLA-1) (CD antigen CD49a)应用: IHC反应种属: Human

鄂公网安备42018502007531号
鄂公网安备42018502007531号

